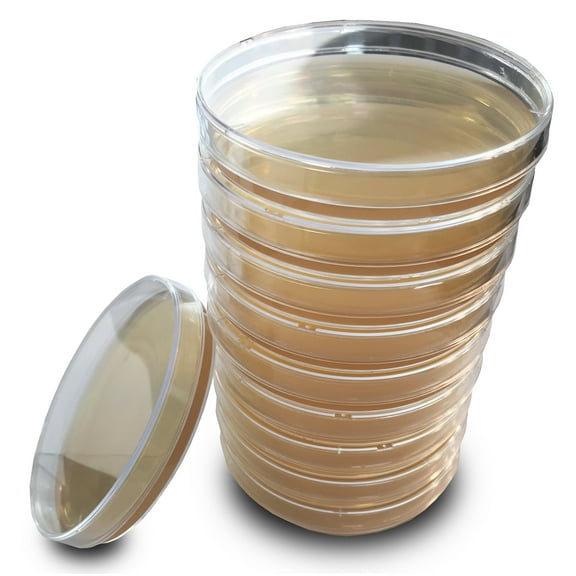
Tryptic Soy Agar (TSA) Plates by Evviva Sciences - Prepoured TSA Petri Dishes - Excellent Performance - Top Science Kit for Science Fair Projects

Evviva Sciences(23)
Uses item details. Price when purchased online
Air Mold Test Kit - Evviva Sciences - 5 Simple Mold Detection Tests - Optional Lab Analysis - Test HVAC System, Room Air, & Home Surfaces - Includes Detailed Mold ID Guide $24.99

$2499
current price $24.99Air Mold Test Kit - Evviva Sciences - 5 Simple Mold Detection Tests - Optional Lab Analysis - Test HVAC System, Room Air, & Home Surfaces - Includes Detailed Mold ID Guide
204.4 out of 5 Stars. 20 reviews
Amazing Bacteria Science Kit - Prepoured Agar Plates Kit - Science Project Kit - Outstanding Performance - Science Project Experiment Ebook Included - Have Fun Learning Microbiology Now $22.99

$2299
current price $22.99Amazing Bacteria Science Kit - Prepoured Agar Plates Kit - Science Project Kit - Outstanding Performance - Science Project Experiment Ebook Included - Have Fun Learning Microbiology Now
Evviva Sciences Mold Detection Test Kit with 10 Individual Tests, 10 Piece

Evviva Sciences Mold Detection Test Kit with 10 Individual Tests, 10 Piece
193.9 out of 5 Stars. 19 reviews
Potato Dextrose Agar Powder 100 Grams - Evviva Sciences - Makes 100-125 Premium Agar Petri Dishes - Premium Performance - Excellent for Mold & Fungus - Great for Mushrooms & Science Projects $33.99

$3399
current price $33.99Potato Dextrose Agar Powder 100 Grams - Evviva Sciences - Makes 100-125 Premium Agar Petri Dishes - Premium Performance - Excellent for Mold & Fungus - Great for Mushrooms & Science Projects
15 out of 5 Stars. 1 reviews
Amazing Owl Pellet Dissection Kit 5-Piece Owl Pellet Set for Science Lab Projects w/Tweezers and Wooden Probes Ideal for Fun Science Projects Barn Owl eBook Included $34.99 Was $44.55

Now$3499
current price Now $34.99, Was $44.55$44.55
Amazing Owl Pellet Dissection Kit 5-Piece Owl Pellet Set for Science Lab Projects w/Tweezers and Wooden Probes Ideal for Fun Science Projects Barn Owl eBook Included
ES EVVIVA SCIENCES Blood Agar Plates with Sterile Cotton Applicators 10 Pre-Poured 10015mm Petri Dishes 5% Defibrinated Sheep Blood on TSA Base Prepared Culture Media Ideal for Lab Training $20.99

$2099
current price $20.99ES EVVIVA SCIENCES Blood Agar Plates with Sterile Cotton Applicators 10 Pre-Poured 10015mm Petri Dishes 5% Defibrinated Sheep Blood on TSA Base Prepared Culture Media Ideal for Lab Training
Tryptic Soy Agar (TSA) Plates by Evviva Sciences - Prepoured TSA Petri Dishes - Excellent Performance - Top Science Kit for Science Fair Projects $28.99
$2899
current price $28.99Tryptic Soy Agar (TSA) Plates by Evviva Sciences - Prepoured TSA Petri Dishes - Excellent Performance - Top Science Kit for Science Fair Projects
Evviva Sciences Mold Test Kit with US-Based Lab Analysis & Return Shipping Included | Screen Indoor Air, HVAC & Surfaces | Professional Mold Presence Detection | Includes Mold Information Guide $44.99

$4499
current price $44.99Evviva Sciences Mold Test Kit with US-Based Lab Analysis & Return Shipping Included | Screen Indoor Air, HVAC & Surfaces | Professional Mold Presence Detection | Includes Mold Information Guide
Mushroom Liquid Culture Premix 100 Grams - Evviva Sciences - Make Liters of Your Own Liquid Culture - Excellent for Mycology $36.90

$3690
current price $36.90Mushroom Liquid Culture Premix 100 Grams - Evviva Sciences - Make Liters of Your Own Liquid Culture - Excellent for Mycology
Agar Variety Kit by Evviva Sciences - Prepoured Potato Dextrose Agar, Malt Extract Agar, & Potato Dextrose Agar w/Activated Charcoal - Premium Performance - Great for Mushrooms & Science Projects $36.99

$3699
current price $36.99Agar Variety Kit by Evviva Sciences - Prepoured Potato Dextrose Agar, Malt Extract Agar, & Potato Dextrose Agar w/Activated Charcoal - Premium Performance - Great for Mushrooms & Science Projects
25 out of 5 Stars. 2 reviews
Potato Dextrose Agar Plates - Evviva Sciences - Prepoured Potato Dextrose Agar PDA Petri Dishes - Excellent Growth Medium - Great for Mushrooms & Science Fair Projects $30.30

$3030
current price $30.30Potato Dextrose Agar Plates - Evviva Sciences - Prepoured Potato Dextrose Agar PDA Petri Dishes - Excellent Growth Medium - Great for Mushrooms & Science Fair Projects
12 out of 5 Stars. 1 reviews
ES EVVIVA SCIENCES Germ Simulation Science Kit Glow-in-the-Dark Powder & Gel - Blacklight Reactive Demonstration - Classroom Lab Activity - Ages 16+ - Simulates Transfer on Hands & Surfaces $25.99

$2599
current price $25.99ES EVVIVA SCIENCES Germ Simulation Science Kit Glow-in-the-Dark Powder & Gel - Blacklight Reactive Demonstration - Classroom Lab Activity - Ages 16+ - Simulates Transfer on Hands & Surfaces
Nutrient Agar Plates by Evviva Sciences - Prepoured Nutrient Agar Petri Dishes - Excellent Growth and Performance - A Great Science Kit for Science Fair Projects $30.99

$3099
current price $30.99Nutrient Agar Plates by Evviva Sciences - Prepoured Nutrient Agar Petri Dishes - Excellent Growth and Performance - A Great Science Kit for Science Fair Projects
15 out of 5 Stars. 1 reviews
Tryptic Soy Agar Powder 100 Grams - Evviva Sciences - Make 100 to 125 Agar Petri Dishes - Excellent for Microbiology - Great for Science Projects $42.99

$4299
current price $42.99Tryptic Soy Agar Powder 100 Grams - Evviva Sciences - Make 100 to 125 Agar Petri Dishes - Excellent for Microbiology - Great for Science Projects
Nutrient Agar Powder 100 Grams - Evviva Sciences - Makes Over 150 to 200 Agar Petri Dishes - Easy to Use - Great Science Fair Projects - W/Experiment Ebook $30.49

$3049
current price $30.49Nutrient Agar Powder 100 Grams - Evviva Sciences - Makes Over 150 to 200 Agar Petri Dishes - Easy to Use - Great Science Fair Projects - W/Experiment Ebook
15 out of 5 Stars. 1 reviews
Sabouraud Dextrose Agar Plates - Evviva Sciences - Excellent for Cultivating Yeasts, Molds, & Other Fungus - 10 Prepoured SDA Petri Dishes - Great for Science Fair Projects! $27.99

$2799
current price $27.99Sabouraud Dextrose Agar Plates - Evviva Sciences - Excellent for Cultivating Yeasts, Molds, & Other Fungus - 10 Prepoured SDA Petri Dishes - Great for Science Fair Projects!
Malt Extract Agar Powder 100g by Evviva Sciences, Can Make Over 100 Agar Petri Dishes, for Mold & Fungus, Ideal for Mushrooms & Science Projects $31.30 Was $35.99

Now$3130
current price Now $31.30, Was $35.99$35.99
Malt Extract Agar Powder 100g by Evviva Sciences, Can Make Over 100 Agar Petri Dishes, for Mold & Fungus, Ideal for Mushrooms & Science Projects
Malt Extract Agar Plates - Evviva Sciences - Great for Mushrooms, Molds, Fungus - 10 Prepoured MEA Petri Dishes - Also Great for Science Fair Projects! $30.30

$3030
current price $30.30Malt Extract Agar Plates - Evviva Sciences - Great for Mushrooms, Molds, Fungus - 10 Prepoured MEA Petri Dishes - Also Great for Science Fair Projects!
25 out of 5 Stars. 2 reviews
Petri Dish 500 Pack 500 Kord Vallmark Petri Dishes 100 X 15mm Premium Performance 3 Vents to Reduce Condensation for Lab Research, Education, & More - W/5 Evviva Transfer Pipettes $147.99

$14799
current price $147.99Petri Dish 500 Pack 500 Kord Vallmark Petri Dishes 100 X 15mm Premium Performance 3 Vents to Reduce Condensation for Lab Research, Education, & More - W/5 Evviva Transfer Pipettes
Amazing Fat Replica 1lb Realistic Anatomic Fat Model Accurate Feel and Appearance of 1 Pound of Fat Great for Students in Physiology & Science Learn Body Fat Anatomy $33.49

$3349
current price $33.49Amazing Fat Replica 1lb Realistic Anatomic Fat Model Accurate Feel and Appearance of 1 Pound of Fat Great for Students in Physiology & Science Learn Body Fat Anatomy
Potato Dextrose Agar Powder 500 Grams - Evviva Sciences - Makes 550 to 600 Agar Petri Dishes - Premium Performance - Excellent for Mold & Fungus - Great for Mushrooms & Science Projects $105.99

$10599
current price $105.99Potato Dextrose Agar Powder 500 Grams - Evviva Sciences - Makes 550 to 600 Agar Petri Dishes - Premium Performance - Excellent for Mold & Fungus - Great for Mushrooms & Science Projects
Malt Extract Agar Plates with Activated Charcoal - Evviva Sciences - Improved - Prepoured Charcoal MEA Petri Dishes - Excellent Growth Medium - Great for Mushrooms & Science Projects $31.99

$3199
current price $31.99Malt Extract Agar Plates with Activated Charcoal - Evviva Sciences - Improved - Prepoured Charcoal MEA Petri Dishes - Excellent Growth Medium - Great for Mushrooms & Science Projects
11 out of 5 Stars. 1 reviews
Evviva Sciences Nutrient Agar Petri Dishes Science Project Kit, Pre-Poured Agar Plates for Science Experiments, with Experiment eBook $26.80

$2680
current price $26.80Evviva Sciences Nutrient Agar Petri Dishes Science Project Kit, Pre-Poured Agar Plates for Science Experiments, with Experiment eBook
Popular in Evviva Sciences
Related Products
Asbestos, Lead, and Mold Combo Test Kit (5 Bus. Days)
Asbestos, Lead, and Mold Combo Test Kit (5 Bus. Days)$105.00current price $105.00gt400 JSP JSP test acid neutralizr 5oz (gt400)
gt400 JSP JSP test acid neutralizr 5oz (gt400)$8.00current price $8.00My Mold Detective MMD103A, 3-Room Kit
My Mold Detective MMD103A, 3-Room Kit$89.99current price $89.99Immunolytics Easy to Use Professional DIY Mold Test Kit for Home - Individual Room Screening Package
Immunolytics Easy to Use Professional DIY Mold Test Kit for Home - Individual Room Screening Package$43.00current price $43.00Alumilite HydroCast Refill Kit 2.2 lbs Casting Kit for Beginners with Matte Ceramic Finish for Decorative Art, Home Decor, Coasters, Jewelry, and Planters
Alumilite HydroCast Refill Kit 2.2 lbs Casting Kit for Beginners with Matte Ceramic Finish for Decorative Art, Home Decor, Coasters, Jewelry, and Planters$7.50current price $7.50Immunolytics DIY Mold Test Kit - Easy to Use Professional 5 Plate Room Screening Kit
Immunolytics DIY Mold Test Kit - Easy to Use Professional 5 Plate Room Screening Kit$39.00current price $39.00Healthful Home Whole Home Mold Inspection Pack - Tests 3 Separate Areas
Healthful Home Whole Home Mold Inspection Pack - Tests 3 Separate Areas$89.98current price $89.98Guaiacol, 250mL - Laboratory-Grade - Appearance: Solid â 82.4F / Liquid â 89.6F - The Curated Chemical Collection by Innovating Science
Guaiacol, 250mL - Laboratory-Grade - Appearance: Solid â 82.4F / Liquid â 89.6F - The Curated Chemical Collection by Innovating Science$90.49current price $90.49ImmunoLytics DIY Mold Test Kit - Easy to Use Precise 3 Swab Kit
ImmunoLytics DIY Mold Test Kit - Easy to Use Precise 3 Swab Kit$118.00current price $118.00Mold Test Kit 5 PK (5 Bus. Days) Schneider Labs
Mold Test Kit 5 PK (5 Bus. Days) Schneider Labs$125.00current price $125.00